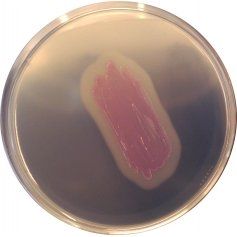

LM852
For detection and differentiation of Listeria monocytogenes from other bacteria in food samples
Package size: 5000 ml
DKK 2.250,00
DKK 750,00
Not in stock, delivery 1-2 weeks
For confirmation of L. monocytogenes species from suspect colonies on CHROMagar™ Listeria (LM852).
The product is composed of a powder base (B) and a supplement (S).
MEDIUM PERFORMANCE:
1. Simplicity/quick results: Classical confirmatory tests for the L. monocytogenes species include many tedious and time consuming steps (purification + catalase + haemolysis + dextrose + rhamnose + xylose...) CHROMagarTM Identification Listeria simplifies the species confirmatory step and reduces the workload, hence improves the efficiency of the laboratory.
2. Clear and distinguishable colors: A single spot of a suspect colony out of CHROMagar™ Listeria directly put onto CHROMagar™ Identification Listeria, will provide confirmation of L. monocytogenes species within 24 hours.
TYPICAL APPEARANCE OF MICROORGANISMS:
L. monocytogenes → rose surrounded by a white halo
L. ivanovii → colourless surrounded by a white halo
L. innocua → rose without halo
B. cereus → colourless with irregular edge (intense halo)
Listeria monocytogenes is a widespread bacteria, present in the soil, sewage, or faecal matter. Its ability to form listerial biofilms on contact surfaces makes it difficult to eliminate. This pathogen can cause serious food poisoning and is therefore frequently isolated in food processing facilities to avoid food contamination. For fast food released onto the market, it is important to rapidly distinguish this pathogen from other harmless Listeria species such as L. ivanovii, L. innocua.
CHROMagar™ has developed a rapid method for the detection of L. monocytogenes in food stuff, comprising the following simple steps (1) enrichement in half frazer broth for 24h, (2) isolation in CHROMagarTM Listeria, (3) confirmation of Listeria monocytogenes species in CHROMagar™ Identification Listeria.